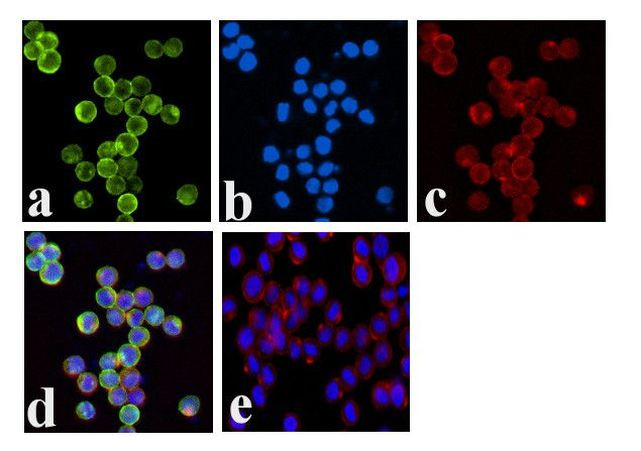
Phospho-JAK1 (Tyr1034, Tyr1035) Antibody in Immunocytochemistry (ICC/IF)

Search
图: 1 / 3
Phospho-JAK1 (Tyr1034, Tyr1035) Antibody (700028) in ICC/IF



产品信息
700028
种属反应
已发表种属
宿主/亚型
Expression System
分类
类型
克隆号
抗原
偶联物
形式
浓度
规格
纯化类型
保存液
内含物
保存条件
运输条件
RRID
产品详细信息
This antibody is predicted to react with mouse, rat, chimpanzee, Rhesus monkey, bovine, canine, porcine, equine, Xenopus and zebrafish based on sequence homology.
Intact IgG appears on a non-reducing gel as ~150 kDa band and upon reduction generating a ~25 kDa light chain band and a ~50 kDa heavy chain.
Recombinant rabbit monoclonal antibodies are produced using in vitro expression systems. The expression systems are developed by cloning in the specific antibody DNA sequences from immunoreactive rabbits. Then, individual clones are screened to select the best candidates for production. The advantages of using recombinant rabbit monoclonal antibodies include: better specificity and sensitivity, lot-to-lot consistency, animal origin-free formulations, and broader immunoreactivity to diverse targets due to larger rabbit immune repertoire.
This product was formerly called "Phospho-JAK1 (Tyr1022, Tyr1023)" because Human Jak1 residues Tyr1034 and Tyr1035 have been historically referenced as Tyr1022 and Tyr1023.
靶标信息
Janus kinase 1 (JAK1), is a protein tyrosine kinase that is involved in the interferon-alpha/beta and -gamma signal transduction pathways. Immunological stimuli, such as interferons and cytokines, induce recruitment of Stat transcription factors to cytokine receptor-associated JAK1. JAK1 then phosphorylates proximal Stat factors, which subsequently dimerize, translocate to the nucleus and bind to cis elements upstream of target gene promoters to regulate transcription. Upon ligand binding, JAK1 undergoes tyrosine phosphorylation and catalytic activation in an interdependent manner. Phosphorylation of tyrosine residues at positions 1022 and 1023 is believed to function in the activation of catalytic events.
仅用于科研。不用于诊断过程。未经明确授权不得转售。
生物信息学
蛋白别名: EC 2.7.10.2; JAK-1; Janus kinase 1; kinase Jak1; Tyrosine-protein kinase JAK1
基因别名: AA960307; AIIDE; BAP004; C130039L05Rik; JAK1; JAK1A; JAK1B; JTK3
UniProt ID: (Human) P23458
Entrez Gene ID: (Human) 3716, (Mouse) 16451